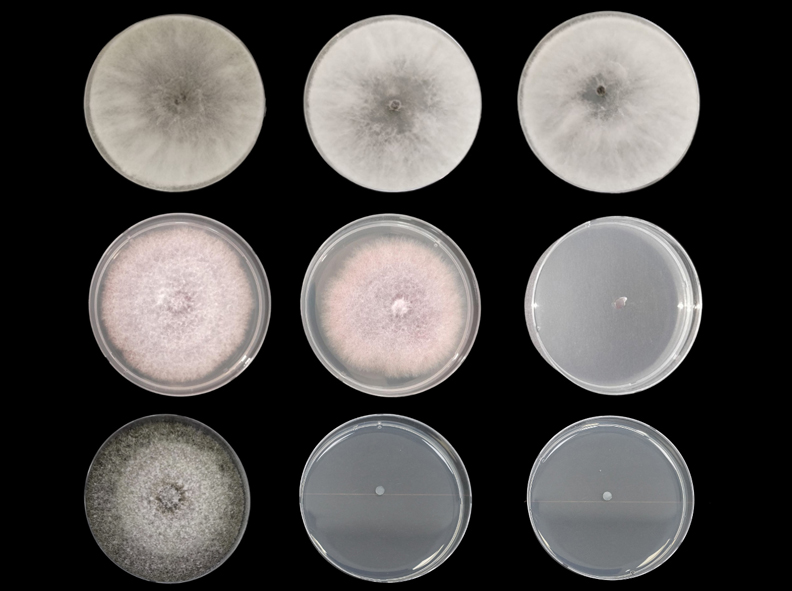

Protege tus cultivos antes y después de cosecha con PERIMAX®
Su acción rápida y potente elimina bacterias, hongos y virus; destaca por su seguridad, ya que no deja residuos tóxicos, y por su eficacia en superficies porosas y no porosas.
Protege tus cultivos antes y después de cosecha con PERIMAX® Leer más »